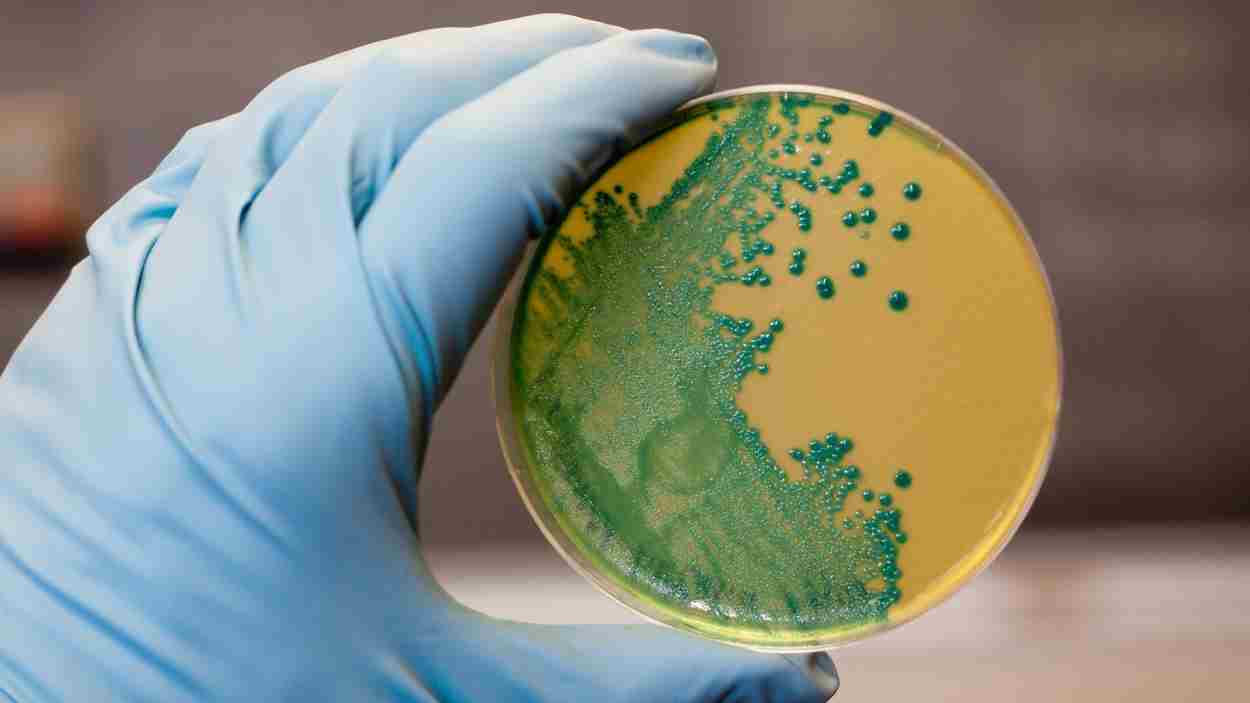
Listeria monocytogenes que crece en una placa de agar. EP.

La Agencia española de Seguridad Alimentaria y Nutrición (AESAN) ha informado este viernes que un lote de embutido envasado contiene Listeria y ha ordenado inmediatamente su retirada de los supermercados.
El producto contaminado se trata de un lote de chopped de lata en lonchas de la marca Nuestra Alacena perteneciente a supermercados DIA. Las autoridades sanitarias de la Junta de Andalucía, a través del sistema Coordinado de Intercambio Rápido de Información (SCIRI), ha sido la responsable de alertar a la AESAN de la presencia de Listeria monocytogenes en el alimento. El lote infectado es el 252771 y cuenta con la fecha de caducidad de 18/11/25. Es un paquete 150 gramos, en lonchas y refrigerado.
Se tiene conocido que la distribución del producto comenzó en Andalucía, pero no se ha descartado que haya podido redistribuirse a otras Comunidades Autónomas. La AESAN ya ha trasladado la información a las autoridades competentes del resto de comunidades mediante el SCIRI para garantizar la retirada de alimentos afectados de los canales de comercialización. De igual forma, el Centro de Coordinación de Alertas y Emergencias Sanitarias (CCAES) también ha sido notificado.
La AESAN ha recomendado a las personas que si poseen el producto afectado en sus casas se deshagan de ellos y eviten consumirlos. Asimismo, han advertido que si alguien ha llegado a ingerir el alimento y presenta síntomas –vómitos, diarrea o fiebre--, acuda al centro de salud.
Además, la agencia ha recalcado que si en el caso de estar embarazada has consumido el alimento deben consultar las recomendaciones que la AESAN ha realizado sobre la situación.
La AESAN ha recalcado la importancia de mantener medidas estrictas de higiene para prevenir la contaminación cruzada en el hogar.
⚠️ Alerta por presencia de Listeria monocytogenes en producto cárnico.
— AESAN (@AESAN_gob_es) November 7, 2025
🚫 No consumir
▶️Nombre: Chopped lata finas lonchas
▶️Marca: Nuestra Alacena (DIA)
▶️N° Lote: 252771
▶️Fecha de caducidad: 18/11/25
📌https://t.co/tYXtY2xz9Z pic.twitter.com/Ct5gY1R6hU
La listeriosis, ¿qué es?
La listeriosis es una enfermedad de transmisión alimentaria causada por la bacteria Listeria monocytogenes. Se caracteriza por resistir a diversas condiciones –como la acidez y las bajas temperaturas–, esto implica que se encuentre ampliamente distribuida tanto en el medio ambiente –suelo, plantas, forraje, materia fecal, aguas residuales, agua– como en los lugares de elaboración de alimentos.
La principal vía de transmisión al ser humano es el consumo de alimentos contaminados, especialmente los alimentos listos para consumo refrigerados con una vida útil relativamente larga, como como los productos del pescado ahumado, los productos cárnicos tratados por calor y los quesos de pasta blanda. La contaminación de los alimentos puede ocurrir en cualquier fase en la que el producto sea expuesto al medio ambiente, incluyendo la elaboración, el transporte, la venta al por menor, los servicios de comidas para colectividades y los hogares.
En personas sanas generalmente la infección se suele manifestar de forma asintomática o cursa con una sintomatología gastrointestinal leve, fiebre y dolores musculares. Sin embargo, en determinados grupos de riesgo, como personas inmunodeprimidas, personas de edad avanzada, niños y embarazadas, pueden presentarse cuadros graves que incluyen meningitis, septicemia, aborto espontáneo, muerte fetal o parto prematuro, entre otros. Aunque la listeriosis es una enfermedad poco frecuente, presenta una elevada tasa de mortalidad en casos graves (30%).
El periodo de incubación suele ser de 1 o 2 semanas, pero puede oscilar entre algunos días y 3 meses. Esto hace que en ocasiones resulte difícil identificar el alimento que está en el origen de la infección.
Síguenos en Google Discover y no te pierdas las noticias, vídeos y artículos más interesantes
Síguenos en Google DiscoverAñadir ElPlural.com como fuente preferida de Google.
Mantente informado con las últimas noticias de actualidad.